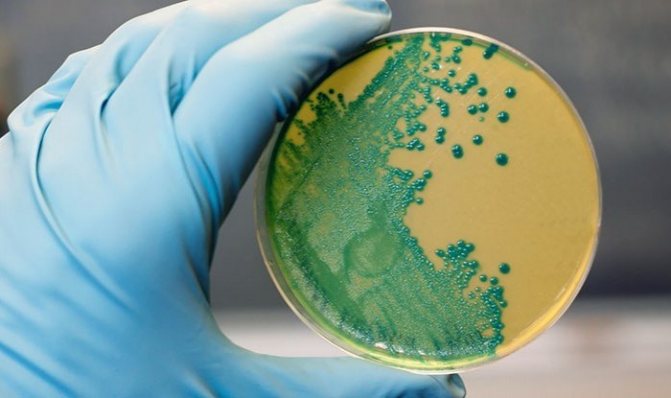

Вакцинация кроликов — ключевой аспект их содержания, защищающий от инфекционных заболеваний, таких как вирусная геморрагическая болезнь кроликов (ВГБК), миксоматоз и пастереллез. В статье рассмотрим необходимые прививки, возраст для вакцинации и используемые препараты. Знание схемы вакцинации и особенностей вакцин поможет обеспечить здоровье и долголетие кроликов, а также предотвратить распространение заболеваний в хозяйстве.
Содержание статьи
Прививка БЦЖ вводится в родильном доме сразу после появления ребенка на свет. У многих родителей возникает естественный вопрос: что собой представляет БЦЖ-прививка, когда и сколько раз ее делают, стоит ли делать ее так рано и не вызовет ли она осложнений.
Туберкулез является серьезной проблемой для стран по всему миру, хотя уровень заболеваемости этой инфекцией варьируется в зависимости от качества медицинского обслуживания и экономического положения государства. До начала вакцинации туберкулез встречался гораздо чаще, и у детей могли развиваться тяжелые поражения не только легких, но и других органов, включая кости, головной мозг и нервную систему. На протяжении многих лет ученые работали над созданием эффективной вакцины, которая была разработана в 1921 году. Однако ее массовое использование в нашей стране началось только с 1950 года. Давайте подробнее рассмотрим, почему новорожденным делают прививку БЦЖ, что означает это название и что важно знать о процессе вакцинации.
Эксперты в области ветеринарии подчеркивают важность вакцинации кроликов для предотвращения распространенных заболеваний. Основными угрозами для здоровья этих животных являются вирусные инфекции, такие как миксоматоз и вирусная геморрагическая болезнь (ВГБ). Миксоматоз, вызываемый вирусом, приводит к серьезным поражениям кожи и внутренних органов, в то время как ВГБ может вызвать внезапную смерть животного. Для защиты кроликов ветеринары рекомендуют использовать вакцины, такие как “Нобивак Микс” и “ВГБ Вак”, которые обеспечивают надежную иммунную защиту. Вакцинация должна проводиться регулярно, начиная с 4-6 недельного возраста, с последующими ревакцинациями раз в год. Это позволяет значительно снизить риск заболеваний и повысить продолжительность жизни кроликов.
Самостоятельное введение
Можно ли вакцинировать питомцев самостоятельно? Да, хотя это не рекомендуется. Начинающим заводчикам, не имеющим возможности оплатить услуги ветеринара или проживающим вдали от соответствующих организаций, желательно на первый раз пригласить опытного соседа. Если вы все же решились делать прививки кроликам в домашних условиях, придерживайтесь нескольких правил.
Самостоятельно вакцинирование при наличии навыков возможно, но не рекомендуется
- Прочитайте инструкцию. Производители качественных препаратов указывают дозировку, сроки ревакцинации, краткое руководство по введению лекарства и другую полезную информацию.
- В зависимости от типа вакцины делают внутримышечные, внутрикожные или подкожные уколы (также описано в инструкции). Места инъекции – бедро, холка, область вокруг уха. Для последнего используют безыгольные приспособления.
- Следите за температурой окружающей среды. Она не должна превышать 28°, иначе организму животного будет тяжелее справляться с введенным вирусом.
- Храните и транспортируйте вакцину правильно. Температура в контейнере должна быть в пределах 2 — 8°. Замораживать препарат категорически воспрещается.
- Если вы приобрели средство в сухом виде, разводите его дистиллированной водой. Вакцинацию такой смесью нужно провести в течение 3 часов после разведения, иначе препарат окажется бесполезным.
| Болезнь | Препарат (вакцина) | Схема вакцинации |
|---|---|---|
| Миксоматоз | Вакцина против миксоматоза кроликов (живая аттенуированная) | Первая вакцинация в 4-6 недель, ревакцинация через 3 месяца, затем каждые 6-9 месяцев |
| Вирусная геморрагическая болезнь кроликов (ВГБК) | Вакцина против ВГБК (инактивированная или живая аттенуированная) | Первая вакцинация в 4-6 недель, ревакцинация через 3 месяца, затем каждые 6-9 месяцев |
| Пастереллез | Вакцина против пастереллеза кроликов (инактивированная) | Первая вакцинация в 4-6 недель, ревакцинация через 2-3 недели, затем каждые 6 месяцев |
| Сальмонеллез | Вакцина против сальмонеллеза кроликов (инактивированная) | Первая вакцинация в 4-6 недель, ревакцинация через 2-3 недели, затем каждые 6 месяцев |
| Колибактериоз | Вакцина против колибактериоза кроликов (инактивированная) | Первая вакцинация в 4-6 недель, ревакцинация через 2-3 недели, затем каждые 6 месяцев |
| Комбинированные вакцины (Миксоматоз + ВГБК) | Вакцины, содержащие компоненты против миксоматоза и ВГБК (например, “Лапимун ГемМикс”, “Нобивак Myxo-RHD”) | Первая вакцинация в 4-6 недель, ревакцинация через 3 месяца, затем каждые 6-9 месяцев |
Интересные факты
Вот несколько интересных фактов о вакцинации кроликов:
-
Основные заболевания: Кроликов вакцинируют от нескольких опасных заболеваний, включая вирусный геморрагический синдром (ВГС) и миксоматоз. Эти болезни могут вызывать массовую гибель животных, и вакцинация является ключевым методом профилактики.
-
Вакцины: Существуют комбинированные вакцины, которые защищают кроликов сразу от нескольких заболеваний. Например, вакцина против ВГС и миксоматоза может вводиться одновременно, что упрощает процесс вакцинации и повышает его эффективность.
-
Иммунный ответ: Вакцинация кроликов не только защищает их от инфекций, но и способствует формированию устойчивого иммунитета. После вакцинации у кроликов вырабатываются антитела, которые помогают организму справляться с инфекциями, если они все же попадут в организм. Важно проводить ревакцинацию, чтобы поддерживать уровень иммунитета на должном уровне.
Сукрольность и вакцинирование
Прививки крольчихам можно делать в любое время, за исключением периода беременности. Во время вынашивания крольчат организм самки испытывает гормональные изменения, а её иммунная система ослаблена, что значительно увеличивает риск заражения инфекциями, от которых проводится вакцинация. Вакцина может оказать негативное влияние как на крольчиху, так и на её потомство. Поэтому вакцинацию следует проводить заранее. Спустя неделю после прививки можно осуществлять случку.
Эффект от вакцины сохраняется на протяжении шести месяцев, что вполне достаточно для вынашивания и кормления потомства. После этого можно проводить ревакцинацию. В случае крайней необходимости, например, при вспышке эпидемии, беременным крольчихам также могут делать прививки. Однако вакцинировать самок в период лактации не рекомендуется.
Опасные болезни и нужные прививки
Выделяют три основных вида опасных для жизни кролика заболеваний: миксоматоз; вирусная геморрагическая болезнь кроликов (ВГБК); бешенство. Обычно лечению они не поддаются и приводят к смертельному исходу.
Прививка от миксоматоза. Миксоматоз — очень опасное инфекционное заболевание. Получен этот вирус был во Франции, более века назад, и был призван для борьбы с быстровозрастающей популяцией кроликов в дикой природе. Но вскоре произошла мутация болезни, и она мгновенно распространилась на домашних животных. Передаётся через укусы комаров и воздушно-капельным путём.
Первыми признаками появления инфекции считаются:
- лихорадка;
- гнойный конъюнктивит;
- отёки;
- опухолевые узлы на теле;
- апатия.
Животные, заболевшие этим заболеванием, погибают в течение двух дней после заражения. Поэтому единственным способом, позволяющим избежать недуга, является проведение вакцинации препаратом Раббивак В.
Время прививки:
- Первый раз делается прививка в месячном возрасте (предпочтительнее весной).
- Через месяц рекомендуется сделать вторую прививку.
- Третий раз прививается животное через полгода (осенью).
В дальнейшем вакцинация повторяется каждые полгода, в весенний и осенний периоды.
Прививка от ВГБК
Вирусная геморрагическая болезнь кроликов представляет собой одну из наиболее опасных инфекционных заболеваний. Основным способом передачи инфекции является контакт с фекалиями уже инфицированных особей, однако в некоторых случаях вирус может передаваться через заражённую почву.
Инкубационный период болезни может длиться до трёх дней. Основные признаки заражения включают:
- Апатия и повышенная сонливость.
- Уменьшение аппетита.
- Проблемы с нервной системой.
- Судороги.
- Аномальные звуки, напоминающие стоны.
Данная болезнь может привести к обширным кровоизлияниям, а также к застойным явлениям в печени и лёгких. К сожалению, эффективных лекарств для лечения этого заболевания не существует, и животное, как правило, погибает в течение нескольких дней. Единственным способом защиты является правильное и своевременное вакцинирование.
Первая вакцинация против вирусной геморрагической болезни кроликов проводится в возрасте полутора месяцев. Если ранее была сделана прививка от миксоматоза, то вакцинацию от ВГБК следует осуществить через две недели.
Через три месяца после первой прививки вводится следующая доза вакцины. Третья вакцинация осуществляется через полгода. Если же наблюдается падёж кроликов в течение нескольких дней после прививки, это может свидетельствовать о том, что заражение произошло до вакцинации.
Прививка от бешенства
Среди кроликов бешенство встречается крайне редко. В случае если кролик подвергся нападению животного заражённого бешенством, то он погибнет в течение недели.
Попадание вируса в кровь животного возможно через слюну и укус больного зверька. Признаки болезни:
- обильное слюнотечение;
- изменения в поведении кролика;
- отказ от воды.
Прививка от бешенства необходима только домашним декоративным кроликам, которые часто совершают поездки с хозяевами в поезде или самолёте. Для прививки используют вакцину общую для всех домашних животных.
Первая инъекция проводится в возрасте около двух месяцев, с последующим повторением каждый год. При необходимости перевозить кролика, вакцинацию проводят за месяц до поездки.
Необязательная вакцинация
Помимо наиболее серьезных заболеваний, кролики могут быть подвержены сальмонеллезу (паратифу), пастереллезу или листериозу.
Вопрос о необходимости вакцинации кроликов и сроках их проведения решает ветеринарный специалист.
Признаки пастереллеза:
- Выделения из глаз.
- Повышенная температура.
- Лихорадка.
Симптомы этого заболевания чаще всего наблюдаются в крупных фермерских хозяйствах, где уход за животными оставляет желать лучшего. Первую вакцинацию проводят в возрасте полтора месяца. В течение следующего года рекомендуется сделать еще две или три ревакцинации. В дальнейшем инъекции следует повторять каждые шесть месяцев.
Симптомы сальмонеллеза:
- интенсивная рвота;
- диарея;
- потеря аппетита.
Схема вакцинации от сальмонеллеза аналогична таковой от пастереллеза, при этом промежуток между вакцинациями должен составлять не менее двух недель.
Листериозом чаще всего страдают крольчихи. У них наблюдается вялость, апатия и отказ от пищи. Существует комплексная вакцина, которая защищает от всех трех заболеваний. График вакцинации разрабатывается ветеринаром.
Какие прививки, и когда делать?
Важен возраст кролика. От него зависит иммунитет животного. Проводить вакцинацию в слишком раннем возрасте опасно. Животное может не перенести упрощенную форму заболевания.
Вакцина – это проникновение возбудителей заболевания в здоровый организм. Организм с ними справляется, в результате чего у него формируется иммунитет к данному заболеванию.
Вакцинируются только здоровых кроликов. Желательно не подвергать животное стрессу.
Первая вакцинация
В идеальных условиях первую вакцинацию кролика рекомендуется проводить в возрасте полутора лет. До этого момента животное получает защитные антитела через материнское молоко. После разлуки с матерью у кролика сохраняется высокий уровень иммунитета в течение тридцати дней. Если же животное заболевает, вакцинацию можно осуществить после трех недель жизни.
Кроликов обычно отнимают от матери в возрасте трех месяцев, но иногда это происходит и в один месяц. В таких случаях вакцинацию следует проводить после достижения крольчонком двухмесячного возраста.
Вакцинация против ВГБК является первой и осуществляется в возрасте одного месяца. Повторная вакцинация проводится через три месяца.
Первая прививка от миксоматоза делается, как правило, в возрасте старше четырех недель, если условия позволяют.
Повторная вакцинация
Маленьким кроликам делают прививку через месяц после первой.
От ВГБК проводятся две повторные прививки в течение двух месяцев после первой вакцинации.
Прививки взрослым кроликам
Взрослым кроликам от ВГБК делают прививки каждые шесть месяцев. Прививка против миксоматоза проводится один раз в год. Это связано с тем, что кролики могут заразиться через укусы кровососущих насекомых.
Прививки беременным и кормящим кроликам
Не существует противопоказаний по поводу прививок. Беременным также их делают. А вот кормящим крольчихам вакцинацию проводить ни в коем случае нельзя, поскольку через молоко возбудители заболеваний могут передаться крольчатам.
Они не смогут справиться с вирусом и могут погибнуть. Все прививки делаются перед беременностью.
Во время беременности крольчихам желательно употреблять комплексные медпрепараты и сыворотки. Проводить процедуру самостоятельно нельзя, только под присмотром ветеринара. За состоянием кролика обязательно следить. При появлении побочных эффектов сразу обращаться к врачу.
От каких болезней прививают кроликов?
Ушастые грызуны сталкиваются с серьезной угрозой в виде инфекционных заболеваний и паразитарных инфекций, которые трудно поддаются лечению. К числу таких болезней относятся:
- миксоматоз;
- вирусная геморрагическая болезнь (ВГБК);
- бешенство;
- листериоз;
- пастереллез;
- сальмонеллез.
Листериоз
Вакцинация против первых двух заболеваний в этом списке является обязательной, что означает, что все кролики получают эти прививки без исключений. Прививки от остальных заболеваний проводятся только в случае вспышек или по желанию владельцев.
Обязательные прививки
Миксоматоз передаётся воздушно-капельным путём от одной особи к другой молниеносно. Также вирус может проникнуть в организм вместе с пищей или через кожу при укусе насекомых. От этой болезни не разработано лечение, питомцы погибают через несколько дней после заражения в 70–100% случаев. Симптомы миксоматоза:
- угнетение;
- шишки на голове и теле;
- отказ от пищи;
- высокая температура;
- гнойные выделения из глаз и носа.
ВГБК – высококонтагиозное инфекционное заболевание, при котором вирус поражает внутренние органы зверька, вызывая в них кровоизлияния. После заражения болезнь протекает скрыто 2–3 дня, после чего возможны 2 варианта развития событий:
- Питомцы гибнут очень быстро без видимых причин, совершая несколько судорожных движений. Владелец кроликов не наблюдает никаких признаков недомогания, а просто обнаруживает их трупы во время очередной раздачи корма.
- Зверьки становятся раздражительными, отказываются от еды, у них случаются судороги. В крольчатнике слышен жалобный писк. Через 2 дня животные умирают. У большинства особей перед смертью из носовых ходов выделяется сукровица.
Необязательные прививки
Прививка от бешенства не является обязательной, однако рекомендуется делать её даже для домашних животных. Вирус, вызывающий это заболевание, представляет серьезную угрозу для человека, так как передаётся через укусы инфицированных животных. Если кролик станет жертвой нападения собаки или дикого животного, заражённого бешенством, вероятность заражения составляет 100%.
При возникновении риска распространения листериоза или пастереллеза ветеринарные службы настоятельно советуют проводить вакцинацию питомцев от этих инфекций. Прививки против данных заболеваний обязательны для животных, участвующих в выставках и других мероприятиях.
Кролики на выставке



Что делать, когда нет возможности обратиться к специалисту (его просто нет или это экономически неоправданно)
Промышленное разведение кроликов подразумевает получение прибыли, а соответственно и затраты должны быть как можно меньше. Поэтому те, кто этим занимается должны сами становиться специалистами, по меньшей мере, уметь сделать укол, дать таблетку, знать, как оказать питомцу первую помощь, самостоятельно сделать прививку.
Самостоятельная вакцинация
Если вы серьезно занимаетесь разведением животных, их численность в вашем хозяйстве может достигать значительных размеров (от 100 и более особей). В таком случае для экономии времени и средств рекомендуется использовать безыгольный инъектор для вакцинации.
Перед тем как проводить прививки кроликам в домашних условиях, важно убедиться в их здоровье. Для этого следует:
Регулярно следить за общим состоянием животных (отсутствие вялости, нормальный аппетит, стул и мочеиспускание). За несколько недель до вакцинации необходимо провести профилактическую дегельминтизацию (использовать глистогонные препараты, подробности можно найти в соответствующем разделе сайта), особенно если плановая дегельминтизация не проводилась более трех месяцев.
Кроме дегельминтизации, важно провести профилактику кокцидиоза (особенно в неблагополучных регионах, что актуально практически для всех мест, подробности можно найти в соответствующем разделе). Если общее состояние кроликов не вызывает сомнений, нужно проверить, что температура тела находится в пределах нормы (от 38,5 до 39,5 градусов). Далее следует внимательно изучить инструкцию к препарату (инструкция обязательно прилагается к каждой упаковке вакцины, что также стоит проверить при покупке). В ней содержится информация о препарате, его дозировке и способах введения.
Существует несколько способов введения: подкожно, внутримышечно и внутрикожно (подробности о технике введения можно найти в разделе, посвященном болезням кроликов). Также на случай возникновения аллергических реакций (одышка, слюнотечение, отек и покраснение слизистых, появление волдырей на теле, шерсть начинает топорщиться) рекомендуется иметь под рукой противоаллергические препараты («супрастин», «тавегил», «дексаметазон» или «дексафорт»), сердечные средства («кофеин» или «сульфокамфокаин»), а также физиологический раствор (NaCl 0,9%) и 5% раствор глюкозы.
При проявлении аллергической реакции у животного необходимо:
- Ввести внутримышечно «супрастин» или «тавегил» в дозе 0,2-0,3 мл, а также подкожно 10-20 мл (в зависимости от веса) физиологического раствора и раствора глюкозы.
- Если в течение 10-15 минут реакция не проходит, следует ввести внутримышечно «дексаметазон» или «дексафорт» в дозе 0,3-0,5 мл. Эти препараты могут снизить эффективность вакцинации, так как, помимо противоаллергического действия, они обладают сильным противовоспалительным эффектом. Поэтому, если пришлось использовать их, лучше повторить вакцинацию через 3-4 недели.
- Если по истечении 15 минут состояние не улучшается, необходимо срочно обратиться за помощью к специалисту. При потере сознания животным или понижении температуры тела следует подкожно ввести 0,2-0,3 мл «кофеина» или «сульфокамфокаина».
После вакцинации важно наблюдать за животным. Аллергическая реакция может проявиться в течение 5-30 минут после инъекции.
Как при вакцинации специалистом, так и в случае самостоятельной вакцинации кроликов, следует помнить, что после процедуры животное может переболеть в легкой форме. В течение 2-3 дней у него может наблюдаться небольшая вялость, снижение аппетита и незначительная припухлость в месте укола. Все эти симптомы являются нормальной реакцией и обычно проходят самостоятельно. Если же через несколько дней они не исчезают или состояние ухудшается, необходимо обратиться к специалисту. Также стоит отметить, что современные вакцины редко вызывают такие реакции, и, как правило, здоровое животное после вакцинации ведет себя так же, как и до нее.
Возраст для прививки
Прививают крольчат в момент отсадки от крольчихи. В разных технологиях выращивания сроки прекращения лактации различаются. Кто-то пытается добиться многократного кроления и производит отсадку в месячном возрасте. Более грамотные кролиководы держат молодняк на молочном прикорме до девяноста дней (акселеративное кролиководство по методу И.Н. Михайлова).
Еще одним критерием для начала прививок служит живой вес крольчонка. Считается, что при массе 500 г и более можно делать первую прививку.
Однако, в сложной ситуации, когда свирепствуют эпидемии, прививают тридцатидневных крольчат. Повторную прививку принято ставить через три месяца, чтобы закрепить иммунитет.
Какую вакцину выбрать для прививки кроликов
Существует множество производителей вакцин для кроликов, однако все они не имеют каких-либо уникальных характеристик. Нельзя утверждать, что вакцина от одного производителя более эффективна, чем от другого. Все они основаны на одном и том же штамме вируса. Основное различие заключается в концентрации и дозировке препарата.
Например, вакцина, разработанная Всероссийским НИИ ветеринарной вирусологии и микробиологии в городе Покров, может быть представлена как в сухом, так и в жидком варианте. Она может быть как ассоциированной, так и инактивированной. В то же время производитель Бионит предлагает только ассоциированную вакцину, отдельно от вакцин против миксоматоза и ВГБК.
Следует отметить, что использование жидкой вакцины более удобно, так как не требуется приобретать отдельный разбавитель и рассчитывать дозировку для разведения. Достаточно просто набрать необходимое количество в шприц и использовать. Это является единственным преимуществом жидкой вакцины.
Опытные кролиководы предпочитают избегать применения двухвалентной инактивированной вакцины. Это связано с тем, что в организм животного вводятся сразу две легкие формы вируса. Иммунной системе легче выработать защиту против одного вируса, а затем, спустя некоторое время, против другого. Одновременная борьба организма с двумя типами вирусов может ослабить животное. В результате это приводит к большему стрессу и снижению прироста веса.
Препараты
Вакцина для кроликов может состоять из живых или инактивированных вирусов. После введения первых иммунитет станет сильнее и выработается быстрее, но организму ушастых зверьков будет тяжело с ними справиться. Последние же вызовут пролонгированный защитный эффект. Также препараты бывают моновалентными и комплексными, то есть, содержащими сразу 2 — 3 вируса, что позволяет сэкономить время и обходится дешевле. Какая из вакцин лучше – решать заводчику, однозначного ответа на этот вопрос нет.
Вакцины содержат один или несколько вирусов
Если вы решили использовать моновалентные препараты, делайте между прививками 2 недели перерыва и ни в коем случае не смешивайте их в одном шприце! Лекарственные средства могут быть несовместимы и при взаимодействии друг с другом вызовут побочные эффекты. К тому же ослабленный организм животного не справится с такой нагрузкой, и кролик заболеет.
Моновалентные
От ВГБК рекомендуют использовать следующие вакцины:
- «Раббивак — V», Россия;
- «Лапимун Гем», Украина;
- «Песторин», Чехия;
- вакцина Покровского завода биологических препаратов, Россия.
Для защиты кроликов от миксоматоза применяются такие моновакцины:
- «Раббивак — В», Россия;
- «Лапимун Микс», Украина;
- «Миксорен», Чехия;
- препарат на основе штамма «В82», Покровский завод, Россия.
Для профилактики пастереллеза рекомендуются:
- «Раббивак — Р», Россия;
- «Пазорин Оль», Чехия.
Для защиты от других заболеваний кроликов используют универсальные вакцины, подходящие для всех животных.
Комбинированные
Ассортимент комплексных прививок для кроликов довольно велик, но чаще применяют вакцины от миксоматоза и вирусной геморрагической болезни. Это двухвалентные препараты, продающиеся в отдельных для каждого вируса флаконах, но совместимые друг с другом. Перед инъекцией жидкости согласно инструкции смешиваются в одном шприце, но побочных эффектов не вызывают:
- «Нобивак Myxo — RHD», Россия-Голландия;
- «Раббивак — VВ», Россия;
- «Лапимун Гемикс», Украина;
- «Песторин Мормикс», Чехия.
Против каждой инфекции имеется ряд вакцин от разных производителей
Подготовка к вакцинации кроликов:
- Обязательно следите за состоянием здоровья вашего кролика.
- Определите массу тела (особенно для крольчат).
- За 10 дней до вакцинации рекомендуется провести профилактическую дегельминтизацию вашего питомца с использованием специальных препаратов для грызунов (или котят), учитывая его вес и следуя инструкциям.
После вакцинации (в течение 14 дней) нельзя:
- Купать кролика и подвергать его резким перепадам температуры.
- Внедрять резкие изменения в рацион.
- Создавать стрессовые ситуации.
- Перевозить.
- Проводить обработку против паразитов.
Вы можете сделать прививки своему кролику в клинике «РодентоВет» (Саратов), предварительно позвонив по номеру 8 (8452) 39-77-40 (регистратура клиники) и записавшись на прием.
Определения:
Миксоматоз – это острое вирусное заболевание, высокоопасное для европейских кроликов вида Oryctolagus cuniculus. Оно проявляется воспалением слизистых оболочек, серозным и серозно-гнойным конъюнктивитом, образованием миксом на коже в области головы, ануса и наружных половых органов, а также формированием студенистых отеков на финальной стадии. Возбудитель миксоматоза – это ДНК-содержащий вирус из семейства Poxviridae рода Leporipoxivirus. Переносчиками являются членистоногие: комары, москиты, кусающие мухи, кроличьи вши и блохи. Кроме того, вирус может передаваться через корма, инвентарь, других животных, птиц, обслуживающий персонал, а также при прямом контакте с больными или переболевшими кроликами.
Вирусная геморрагическая болезнь кроликов – это инфекционное заболевание, передающееся контактным путем, вызываемое вирусом и характеризующееся острым течением с летальностью, достигающей 100 %. При молниеносном течении болезни симптомы могут отсутствовать, и скоропостижная смерть может наступить всего через 3-4 часа после осмотра внешне здорового кролика. Лечение этой болезни не разработано.
В нашей стране производятся два типа вакцин для кроликов: моновакцины – против одного заболевания (миксоматоза или ВГБК) и ассоциированные вакцины (одновременно против миксоматоза и ВГБК). Также с 2014 года доступна импортная вакцина для кроликов от компании Нобивак.
Мы надеемся, что смогли полностью ответить на вопрос о необходимости вакцинации кроликов и связанных с этим аспектах.
Ветеринарный врач, квн, Казаков Артем Аркадьевич
Ред. 08.2020
Вакцинация беременных и кормящих крольчих
Осуществлять вакцинацию беременным крольчихам не рекомендуется. Когда возникает такая необходимость, оптимально произвести укол на небольшом сроке, задолго до родоразрешения. Кормящих крольчих прививать запрещено.
Иммунитет у детенышей формируется в процессе питания молоком матери. Потому целесообразно выждать определенный промежуток времени и вакцинировать уже окрепших крольчат. Оптимально прививать маленьких кроликов весной.
Во избежание неблагоприятных последствий, крольчих прививают за 1,5 недели до вязки. В такой ситуации организм сможет вовремя выработать антитела к заболеванию. Ввиду этого вакцинация беременных самок осуществляется нечасто.
В каком возрасте можно прививать?
Существует множество видов прививок, и владельцам животных важно знать, какие из них необходимо делать и в какие сроки. Это напрямую влияет на эффективность вакцинации. Также следует учитывать возраст питомца.
Опытные заводчики кроликов знают, что эти животные подвержены стрессам, особенно молодые крольчата, что может привести к снижению их иммунной защиты. Эффективность вакцины зависит от наличия в ней ослабленных возбудителей определенных заболеваний, и иммунитет повышается, когда организм успешно справляется с ними. Поэтому не рекомендуется делать прививки ослабленным животным, так как это может причинить им вред. Вакцинацию следует проводить только после достижения кроликами возраста 45 дней. В случае угрозы жизни прививки можно делать уже на третьей-четвертой неделе, однако более ранние вакцинации могут быть опасны.
Многие начинающие кролиководы задаются вопросом, как часто нужно делать прививки своим питомцам. Обычно рекомендуется проводить вакцинацию не чаще одного раза в полгода. Однако в этом случае важно учитывать характер заболевания. Подход к определению частоты прививок от миксоматоза должен быть индивидуальным. Специалисты отмечают, что это заболевание передается через комаров, блох и мух. В осенне-зимний период комары и мухи практически не активны из-за низких температур. Поэтому в регионах с умеренно-континентальным климатом вакцинацию кроликов от миксоматоза можно проводить не чаще одного раза в год.
Вакцинация от миксоматоза
открытие он совершил более 100 лет назад
Однако ученый не учел всех последствий: болезнь стала быстро распространяться и вирус мутировал. Сложность лечения миксоматоза обусловлена тем, что она предусматривает множество способов распространения: помимо традиционных переносчиков — комаров и блох вирус может попасть в организм животного воздушным путем.
Для этого заболевания характерны следующие симптомы:
- отеки век и глаз;
- высокая температура;
- апатия.
Если не предпринять экстренных мер, то смерть животного наступает уже через 48 часов. Своевременная вакцинация — это единственный способ предотвратить появления этого заболевания.
Перед вакцинацией кроликов необходимо иметь в виду, что все прививки должны делаться в соответствии с определенными правилами, иначе их эффективность будет низкой.
Прививки смогут защитить животное от опасных вирусов, если придерживаться следующей схемы:
- В первый раз вакцинацию проводят весной, причем делать ее можно лишь животным в возрасте не менее 4 недель;
- Во второй раз прививки делают через 28-30 дней после проведения первой.
- В последний раз вакцинацию проводят спустя полгода (осенью).
Впоследствии прививки кроликам нужно делать не реже одного раза в год или каждые полгода. Однако в некоторых случаях при благоприятных для развития болезни условиях частоту прививок разрешается увеличить. Прививки будут максимально эффективными, если их делать здоровым животным.
Вакцинация от ВГБК
Вирусная геморрагическая болезнь кроликов представляет собой серьезную угрозу для здоровья этих животных. Она может передаваться различными способами: через инфицированных особей, пищу, почву или даже человека. Первые симптомы заболевания могут проявиться уже через два-три дня после заражения. К ним относятся потеря аппетита, вялость и нарушения в работе нервной системы. При этом заболевании страдают все органы животного. Учитывая стремительное развитие болезни, вакцинация становится необходимой мерой.
Существует определенная схема вакцинации, которой следует придерживаться:
- Первую прививку делают крольчатам в возрасте 45 дней;
- Если животные уже были вакцинированы от миксоматоза, то прививку против ВГБК можно проводить через 2 недели. То же самое касается случаев, когда первый укол был сделан против ВГБК;
- Последующие два этапа вакцинации осуществляются с интервалом в 14 дней;
- Повторные прививки необходимо делать каждые полгода.
Осложнения после прививки
Обычно здоровые кролики хорошо переносят прививки. Им требуется несколько часов для адаптации, связанной со стрессом. В некоторых случаях возможны аллергические реакции на вакцину, которые развиваются в течение 15 минут после укола и проявляются такими симптомами:
- покраснение слизистых оболочек;
- слюнотечение;
- сыпь на коже;
- одышка;
- вялость и потеря сознания.
Для купирования аллергической реакции кролику вводят внутримышечно антигистаминные средства — «Димедрол» или «Супрастин» в дозе 0,2–0,3 мл. Для поддержания сердечной деятельности подкожно вводят 0,2–0,3 мл раствора «Кофеин-бензоат натрия» или «Сульфокамфокаин» и 10–20 мл физраствора.
После прививки кроликам через сколько можно их забивать? Большинство производителей вакцин указывают, что срока ожидания после введения препарата нет. И тем не менее не рекомендуется проводить убой в течение недели, так как в месте укола могут быть различные воспалительные реакции, снижающие товарный вид тушки.
Итак, повторим, какие прививки нужно делать кроликам, чтобы обезопасить питомцев от инфекционных болезней. Это прежде всего миксоматоз и вирусная геморрагическая болезнь. Их предупреждают введением комплексной вакцины в начале весны. Через полгода осенью исходя из показаний может быть проведена прививка от ВГБК моновакциной. Инфекции, распространённые в вашем местности, от которых необходимо прививать кроликов дополнительно, нужно узнать местной районной ветеринарной станции.
Частота вакцинации: основные моменты
В современной ветеринарной практике рекомендуется делать прививки кроликам каждые шесть месяцев. Это обеспечивает надежную защиту питомца от большинства заболеваний и значительно снижает риск заражения серьезными инфекциями.
Большинство вакцин, включая прививку от геморрагической болезни (ГБ), следует вводить каждые девять месяцев. Важно учитывать и сезонные факторы. Например, миксоматоз передается через укусы кровососущих насекомых, поэтому лучше проводить вакцинацию перед началом летнего периода. В зимнее время ревакцинация нецелесообразна, так как в это время года насекомые отсутствуют.
Схемы вакцинации
Не менее важен вопрос о том, когда и через какое время следует осуществлять введение вакцины для кроликов. В идеале первую прививку делают кроликам, достигшим возраста 45 дней и набравшим вес не менее 500 гр. Последующее введение вакцины осуществляется через каждые полгода на протяжении всей жизни. Е
сли отсутствует информация о том, имела ли место прививка для кроликов или нет, либо был допущен большой перерыв, то начинать вакцинацию можно и нужно в любом возрасте. Главное, четко придерживаться плана, который подсказывает когда надо делать прививки, и следование которому гарантирует оптимальную защиту от инфицирования.
Существует 2 схемы, в соответствии с которыми и нужно строить план прививок. В соответствии с первым вариантом планирования прививок, процесс можно разделить на следующие этапы:
- прививание в 45-ти дневном возрасте ассоциированной вакциной;
- ревакцинация спустя 3 месяца;
- впоследствии рекомендуется делать прививки с периодичностью каждые полгода.
Вторая схема состоит из таких шагов:
- первая прививка для кроликов делается в том же полуторамесячном возрасте, только уже не комплексной, а моновакциной, в большинстве случаев это именно ВГБК;
- спустя 2 недели следует вакцинация от миксоматоза;
- по прошествии того же срока закрепляется эффект вакцины ВГБК;
- опять же через 14 дней делается прививка от миксоматоза;
- 3 месяца спустя производится введение ассоциированной вакцины;
- затем следует период ревакцинации, когда прививки необходимо делать через каждые 6 месяцев.
После прививки необходимо выдержать 14-дневный карантин, чтобы обезопасить питомца от возможного инфицирования, пока вакцина не начала своего действия. Нужно больше давать тыкву, рыбий жир, рябину, пророщенные зерна. В этот период необходимо ввести в рацион зверька витаминные добавки, иммуностимулирующие препараты. Когда речь идет о допуске на выставки, то вакцинация кроликов, участвующих в мероприятиях подобного рода, должна осуществляться за 2-4 недели до события и документироваться в ветпаспорте, куда заносятся все замечания по этому поводу.
Приняв во внимание все вышеизложенные рекомендации и советы, проявляя внимательное отношение к вопросам о прививках для кроликов, можно избежать многих неприятных проблем, обеспечив своему питомцу по-настоящему крепкое здоровье
Полезные советы
Вакцинация не всегда гарантирует защиту вашему питомцу. Это может произойти по нескольким причинам: крольчонок мог заразиться до проведения прививки, использовалась просроченная вакцина, или же питомец был ослаблен другими заболеваниями.
Также стоит учитывать, что после вакцинации крольчат могут возникнуть осложнения. Это может случиться, если перед прививкой не была проведена обработка от глистов, если вакцинировался больной крольчонок или слишком маленький питомец. Проблемы могут возникнуть и в случае вакцинации беременной или кормящей самки. Поэтому лучше избегать вакцинации таких животных, особенно на поздних сроках, чтобы не навредить будущим крольчатам.
Когда делать прививку нельзя
При определённых обстоятельствах животное не нуждается в проведении вакцинации. В таком случае прививка отрицательно скажется на здоровье кролика, возможен даже летальный исход. Выделяют несколько подобных ситуаций.
Период лактации
Когда крольчиха выкармливает своих малышей после беременности, ей не требуется вакцинация. Вакцинация может оказать негативное влияние на маленьких кроликов, так как в материнское молоко попадут компоненты инъекционного препарата, содержащие различные микроорганизмы.
Кролик уже болеет
Крайне не рекомендуется прививать питомца, если он уже заражён. В сложившейся ситуации препарат усугубит ситуацию, и зверьку станет только хуже. Питомца сначала нужно вылечить, а уже потом применять профилактические меры по укреплению его иммунитета.
В период вязки
Если кто-то решил заняться разведением декоративных кроликов, то в течение этого периода прививки делать не следует. Это может негативно повлиять на процесс спаривания, беременность самок, а также на здоровье новорожденных крольчат.
Осложнения
Если прививки сопровождаются негативными последствиями, лучше от вакцинации воздержаться. Речь идёт о необязательных вакцинах, которые в некоторых случаях отрицательно воспринимаются организмом кролика. Речь идёт о повышении температуры тела после прививки, вздутии кожи, апатии и т. д.
Вакцинация питомца против ВГБК через полгода после рождения
Обратите внимание! Второстепенные вакцины вводятся только по необходимости, когда у питомца наблюдаются те или иные симптомы
Рекомендации по уходу за кроликами после вакцинации
После вакцинации кроликов важно обеспечить им правильный уход, чтобы минимизировать риск осложнений и поддержать иммунный ответ. В первые дни после прививки следует обратить внимание на несколько ключевых аспектов.
1. Наблюдение за состоянием здоровья: В течение 48 часов после вакцинации необходимо внимательно следить за поведением и состоянием кролика. Обратите внимание на аппетит, активность и общее самочувствие. Если животное проявляет вялость, отказывается от корма или воды, это может быть признаком реакции на вакцину, и в таком случае стоит обратиться к ветеринару.
2. Условия содержания: Важно обеспечить кроликам комфортные условия. Температура в помещении должна быть стабильной, избегайте сквозняков и резких перепадов температуры. Убедитесь, что клетка чистая и сухая, а подстилка свежая. Это поможет предотвратить развитие инфекций и снизит стресс для животного.
3. Ограничение физической активности: В первые несколько дней после вакцинации рекомендуется ограничить физическую активность кроликов. Это поможет избежать излишнего стресса на организм и даст возможность иммунной системе сосредоточиться на выработке антител. Избегайте резких движений и активных игр.
4. Правильное питание: Обеспечьте кроликам полноценное и сбалансированное питание. В рацион должны входить свежие овощи, сено и качественные гранулы. Избегайте резких изменений в питании, так как это может вызвать стресс и негативно сказаться на здоровье животного.
5. Вакцинация и другие процедуры: Не рекомендуется проводить другие медицинские процедуры, такие как стрижка или обработка от паразитов, в течение недели после вакцинации. Это поможет избежать дополнительного стресса и снизит риск осложнений.
6. Вакцинация в будущем: Обратите внимание на график вакцинации и ревакцинации, который должен быть составлен ветеринаром. Регулярные прививки помогут защитить кроликов от опасных заболеваний и поддерживать их здоровье на должном уровне.
Следуя этим рекомендациям, вы сможете обеспечить своим кроликам комфортный и безопасный период восстановления после вакцинации, что в свою очередь поможет укрепить их иммунитет и защитить от заболеваний.
Вопрос-ответ
От чего нужно вакцинировать кроликов?
Вакцинация кроликов – это важнейший способ профилактики инфекционных заболеваний. Кроликов, содержащихся в городской квартире, вакцинируют от вирусной геморрагической болезни кроликов и от миксоматоза.
Какие вакцины следует делать кроликам?
Для кроликов доступны различные вакцины, в том числе комбинированные вакцины, которые обеспечивают ежегодную защиту как от миксоматоза, так и от вирусной инфекции брюшного тифа (R(V)HD). Кроликов можно вакцинировать с пятинедельного возраста. Также вам понадобится отдельная вакцина для защиты от вирусной инфекции брюшного тифа (R(V)HD2) в возрасте 10 недель.
Комплексная вакцина для кроликов цена?
265 руб. Вакцина против миксоматоза и ВГБК для кроликов – биопрепарат российского производителя ГНУ ВНИИВВиМ Россельхозакадемии (ФГБНУ ФИЦВиМ), способствующий формированию устойчивого иммунитета к смертельно опасным инфекциям: миксоматозу и вирусной геморрагической болезни кроликов типа 1 и типа 2.
Сколько раз нужно вакцинировать кролика?
Первичная вакцинация 1,5 месяца при весе 500 грамм. Ревакцинация проходит в 4,5 месяца. Повторная вакцинация происходит каждые 9 месяцев. Вакцинацию выполняют с целью иммунизации здоровых особей одноразово, начиная с 1,5 месячного возраста.
Советы
СОВЕТ №1
Перед вакцинацией обязательно проконсультируйтесь с ветеринаром. Он поможет определить, какие вакцины необходимы вашему кролику в зависимости от его возраста, состояния здоровья и условий содержания.
СОВЕТ №2
Следите за графиком вакцинации. Вакцины для кроликов обычно вводятся в определенные сроки, поэтому важно соблюдать рекомендованный график, чтобы обеспечить максимальную защиту от болезней.
СОВЕТ №3
Обратите внимание на возможные побочные эффекты после вакцинации. Наблюдайте за состоянием вашего кролика в течение нескольких дней после прививки и при появлении необычных симптомов немедленно обращайтесь к ветеринару.
СОВЕТ №4
Не забывайте о регулярной ревакцинации. Некоторые вакцины требуют повторного введения через определенные интервалы времени, чтобы поддерживать иммунитет вашего кролика на должном уровне.
После вакцинации кроликов важно обеспечить им правильный уход, чтобы минимизировать риск осложнений и поддержать иммунный ответ. В первые дни после прививки следует обратить внимание на несколько ключевых аспектов.
1. Наблюдение за состоянием здоровья: В течение 48 часов после вакцинации необходимо внимательно следить за поведением и состоянием кролика. Обратите внимание на аппетит, активность и общее самочувствие. Если животное проявляет вялость, отказывается от корма или воды, это может быть признаком реакции на вакцину, и в таком случае стоит обратиться к ветеринару.
2. Условия содержания: Важно обеспечить кроликам комфортные условия. Температура в помещении должна быть стабильной, избегайте сквозняков и резких перепадов температуры. Убедитесь, что клетка чистая и сухая, а подстилка свежая. Это поможет предотвратить развитие инфекций и снизит стресс для животного.
3. Ограничение физической активности: В первые несколько дней после вакцинации рекомендуется ограничить физическую активность кроликов. Это поможет избежать излишнего стресса на организм и даст возможность иммунной системе сосредоточиться на выработке антител. Избегайте резких движений и активных игр.
4. Правильное питание: Обеспечьте кроликам полноценное и сбалансированное питание. В рацион должны входить свежие овощи, сено и качественные гранулы. Избегайте резких изменений в питании, так как это может вызвать стресс и негативно сказаться на здоровье животного.
5. Вакцинация и другие процедуры: Не рекомендуется проводить другие медицинские процедуры, такие как стрижка или обработка от паразитов, в течение недели после вакцинации. Это поможет избежать дополнительного стресса и снизит риск осложнений.
6. Вакцинация в будущем: Обратите внимание на график вакцинации и ревакцинации, который должен быть составлен ветеринаром. Регулярные прививки помогут защитить кроликов от опасных заболеваний и поддерживать их здоровье на должном уровне.
Следуя этим рекомендациям, вы сможете обеспечить своим кроликам комфортный и безопасный период восстановления после вакцинации, что в свою очередь поможет укрепить их иммунитет и защитить от заболеваний.
После вакцинации кроликов важно обеспечить им правильный уход, чтобы минимизировать риск осложнений и поддержать иммунный ответ. В первые дни после прививки следует обратить внимание на несколько ключевых аспектов.
1. Наблюдение за состоянием здоровья: В течение 48 часов после вакцинации необходимо внимательно следить за поведением и состоянием кролика. Обратите внимание на аппетит, активность и общее самочувствие. Если животное проявляет вялость, отказывается от корма или воды, это может быть признаком реакции на вакцину, и в таком случае стоит обратиться к ветеринару.
2. Условия содержания: Важно обеспечить кроликам комфортные условия. Температура в помещении должна быть стабильной, избегайте сквозняков и резких перепадов температуры. Убедитесь, что клетка чистая и сухая, а подстилка свежая. Это поможет предотвратить развитие инфекций и снизит стресс для животного.
3. Ограничение физической активности: В первые несколько дней после вакцинации рекомендуется ограничить физическую активность кроликов. Это поможет избежать излишнего стресса на организм и даст возможность иммунной системе сосредоточиться на выработке антител. Избегайте резких движений и активных игр.
4. Правильное питание: Обеспечьте кроликам полноценное и сбалансированное питание. В рацион должны входить свежие овощи, сено и качественные гранулы. Избегайте резких изменений в питании, так как это может вызвать стресс и негативно сказаться на здоровье животного.
5. Вакцинация и другие процедуры: Не рекомендуется проводить другие медицинские процедуры, такие как стрижка или обработка от паразитов, в течение недели после вакцинации. Это поможет избежать дополнительного стресса и снизит риск осложнений.
6. Вакцинация в будущем: Обратите внимание на график вакцинации и ревакцинации, который должен быть составлен ветеринаром. Регулярные прививки помогут защитить кроликов от опасных заболеваний и поддерживать их здоровье на должном уровне.
Следуя этим рекомендациям, вы сможете обеспечить своим кроликам комфортный и безопасный период восстановления после вакцинации, что в свою очередь поможет укрепить их иммунитет и защитить от заболеваний.